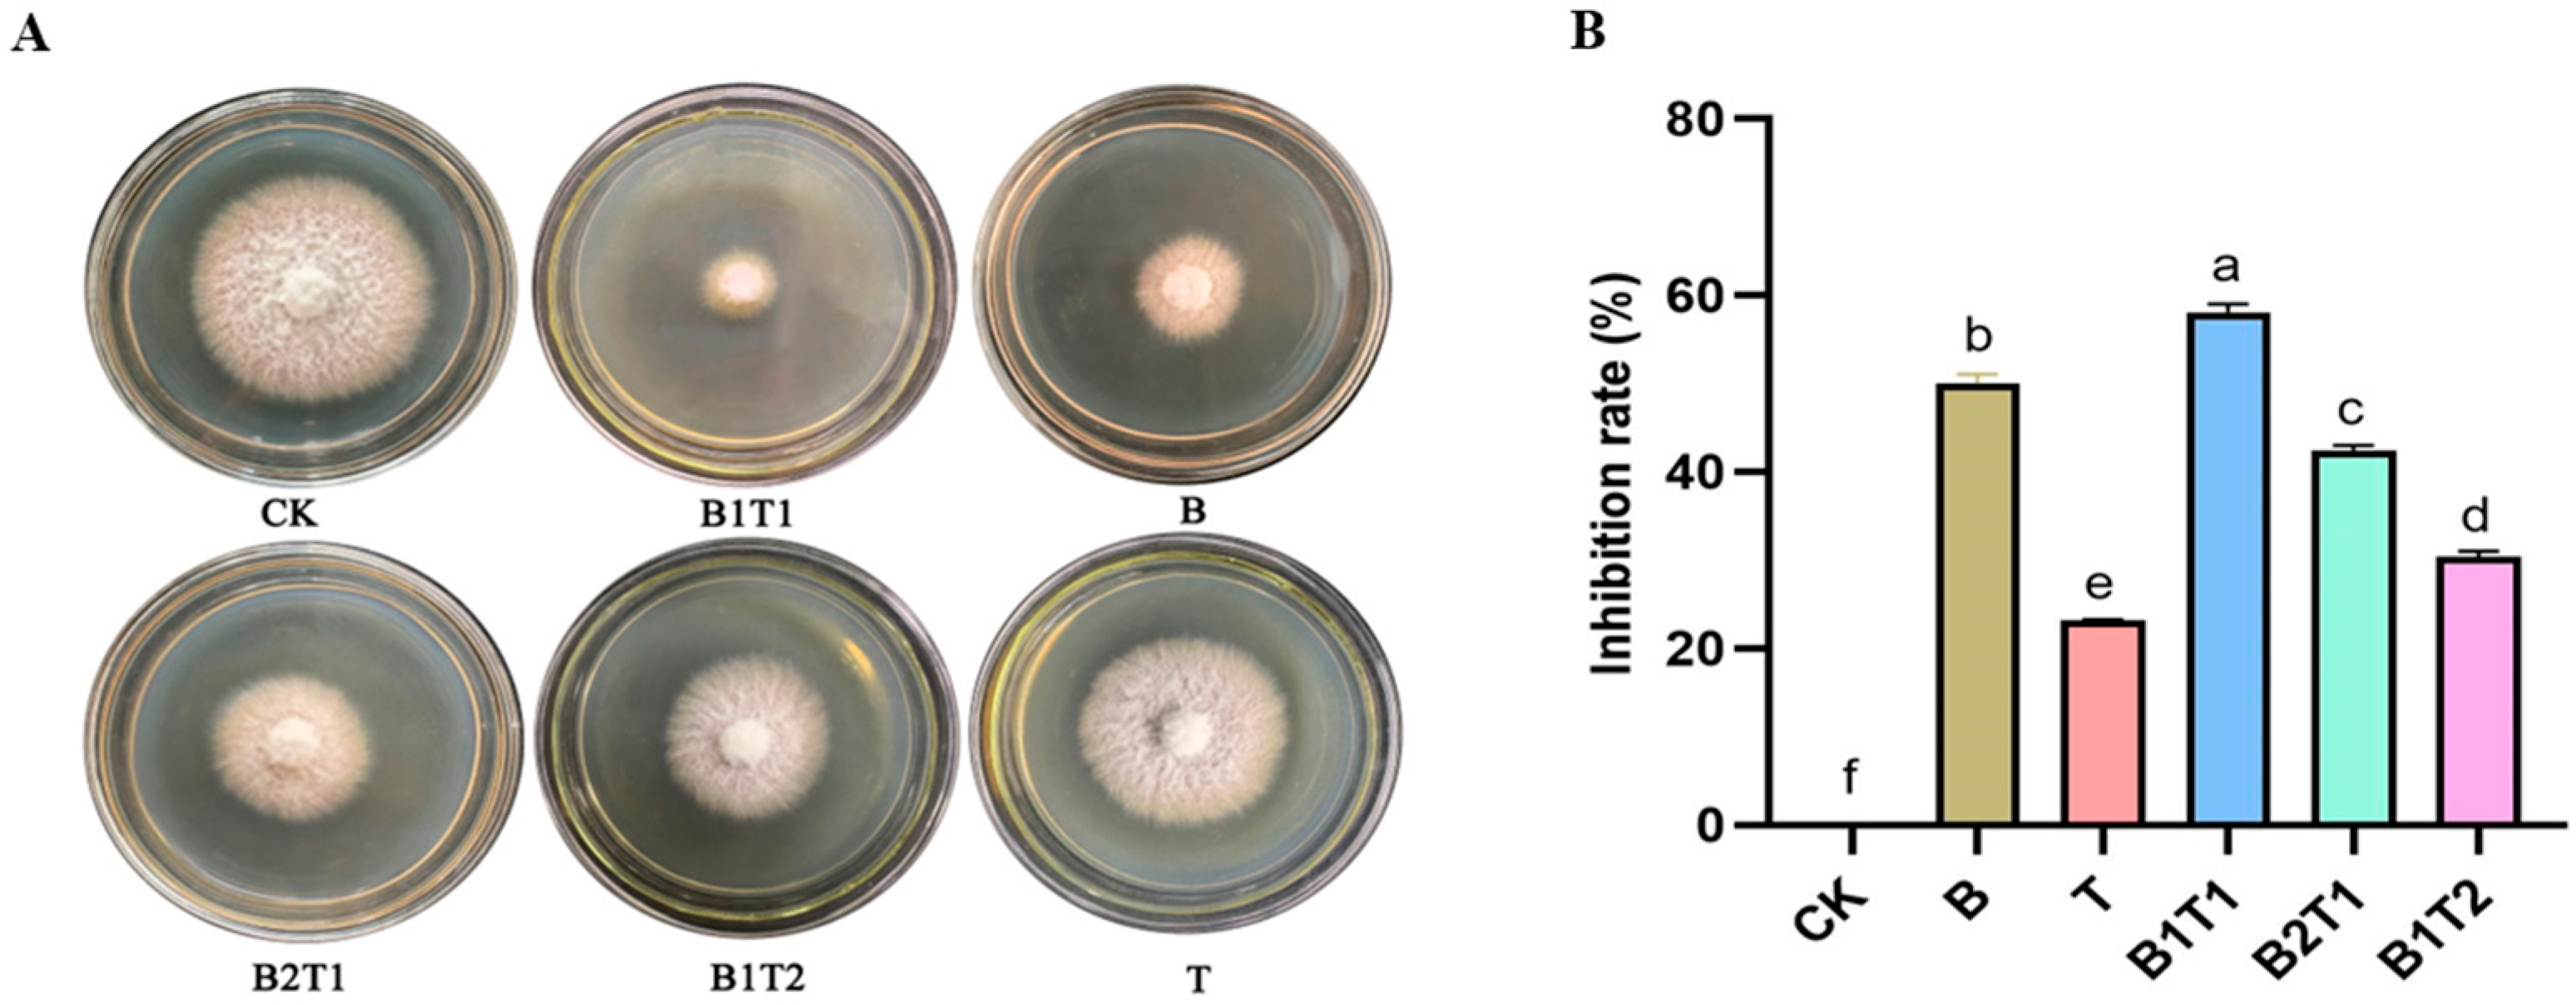
Plants 13 00925 g001

Inhibition of Potato Fusarium Wilt by Bacillus subtilis ZWZ-19 and Trichoderma asperellum PT-29: A Comparative Analysis of Non-Targeted Metabolomics
Abstract
:1. Introduction
2. Materials and Methods
2.1. Pathogens, Biocontrol Strains, and Plants
2.2. Preparation of the Fermentation Broth and Observation of Morphological Characteristics among Different Culture Methods
2.3. Inhibition of F. oxysporum ZY-7 by Fermentation Solution
2.4. Control Effect of the Fermentation Broth on Potato Fusarium Wilt
2.5. LC-MS/MS Analysis of the Fermentation Broth of T. asperellum PT-29 and B. subtilis ZWZ-19 Co-Culture
2.6. Metabolomics Data Analysis
3. Results
3.1. Morphological Characteristics of B. subtilis ZWZ-19 and T. asperellum PT-29 and Their Inhibitory Effects on F. oxysporum
3.2. Annotation and Multivariate Statistical Analysis of Metabolites
3.3. Analysis of Differential Metabolites in Single- and Co-Culture Fermentation Solutions of B. subtilis ZWZ-19 and T. asperellum PT-29
3.4. Comprehensive Comparison of Metabolite Differences
3.5. Comparison of Amino Acid Production in Fermentation Broths
3.6. KEGG Signal Pathway Analysis of Differential Metabolites
3.7. Correlation Analysis of Differential Metabolites
4. Discussion
5. Conclusions
Supplementary Materials
Author Contributions
Funding
Data Availability Statement
Acknowledgments
Conflicts of Interest
References
- Ding, K.; Wang, L.; Tian, G.; Wang, H.; Li, F.; Pan, Y.; Pang, Z.; Shan, Y. Response of potato growth and physiological characteristics to water stress. Crops 2023, 4, 16–21. [Google Scholar] [CrossRef]
- Liu, Y.; Yi, X.; Luo, Q.; Gao, M.; Zhang, M. Analysis of potato trade and marketing strategy in China. Chin. Agric. Sci. Bull. 2016, 32, 180–185. [Google Scholar]
- Jia, R.; Kang, L.; Zhao, Y.; An, L.; Zhang, Z.; Zhao, J.; Xu, L.; Zhang, J. Isolation, identification and their biological characteristics of pathogens of potato Fusarium wilt in Yinshan area, Inner Mongolia. J. Zhejiang Univ. 2023, 49, 65–75. [Google Scholar]
- Jansky, S.; Jin, L.; Xie, K.; Xie, C.; Spooner, D. Potato production and breeding in China. Potato Res. 2009, 52, 57–65. [Google Scholar] [CrossRef]
- Li, J.; Li, M.; Hui, N.; Wang, L.; Ma, Y.; Qi, Y. Population dynamics of major pathogenic fungi in soil of potato continuous cropping fields. Acta Prataculturae Sin. 2016, 22, 147–152. [Google Scholar]
- Gao, Z.; Hu, Y.; Han, M.; Xu, J.; Wang, X.; Liu, L.; Tang, Z.; Jiao, W.; Jin, R.; Liu, M. Effects of continuous cropping of sweet potatoes on the bacterial community structure in rhizospheric soil. BMC Microbiol. 2021, 21, 102. [Google Scholar] [CrossRef] [PubMed]
- Osdaghi, E.; van der Wolf, J.M.; Abachi, H.; Li, X.; De Boer, S.H.; Ishimaru, C.A. Bacterial ring rot of potato caused by Clavibacter sepedonicus: A successful example of defeating the enemy under international regulations. Mol. Plant Pathol. 2022, 23, 911–932. [Google Scholar] [CrossRef] [PubMed]
- Xia, S.; Niu, Z.; Li, Q.; Zhang, L.; Sheng, W. Research progress and control measures of Fusarium wilt of potato. Heilongjiang Agric. Sci. 2022, 2, 89–94. [Google Scholar]
- Xu, S.; Xie, X.W.; Zhang, Y.; Shi, Y.; Chai, A.; Li, L.; Li, B. Screening of biocontrol Bacillus isolate against potato Fusarium wilt and Its biocontrol effect. Chin. J. Biol. Control 2020, 36, 761–770. [Google Scholar] [CrossRef]
- Li, L.; Zhu, T.; Song, Y.; Feng, L.; Kear, P.J.; Riseh, R.S.; Sitohy, M.; Datla, R.; Ren, M. Salicylic acid fights against Fusarium wilt by inhibiting target of rapamycin signaling pathway in Fusarium oxysporum. J. Adv. Res. 2022, 39, 1–13. [Google Scholar] [CrossRef]
- Ben Khedher, S.B.; Mejdoub-Trabelsi, B.; Tounsi, S. Biological potential of Bacillus subtilis V26 for the control of Fusarium wilt and tuber dry rot on potato caused by Fusarium species and the promotion of plant growth. Biol. Control 2021, 152, 104444. [Google Scholar] [CrossRef]
- Collinge, D.B.; Jensen, D.F.; Rabiey, M.; Sarrocco, S.; Shaw, M.W.; Shaw, R.H. Biological control of plant diseases–what has been achieved and what is the direction? Plant Pathol. 2022, 71, 1024–1047. [Google Scholar] [CrossRef]
- Ferreira, F.V.; Musumeci, M.A. Trichoderma as biological control agent: Scope and prospects to improve efficacy. World J. Microbiol. Biotechnol. 2021, 37, 90. [Google Scholar] [CrossRef] [PubMed]
- Li, Z.; Li, X.; Ren, Y. Role of Trichoderma viride histone deacetylase gene TvRpd3 in the biocontrol of Trichoderma. Acta Microbiol. Sin. 2023, 63, 3560–3573. [Google Scholar] [CrossRef]
- Wu, Q.; Ni, M.; Dou, K.; Tang, J.; Ren, J.; Yu, C.; Chen, J. Co-culture of Bacillus amyloliquefaciens ACCC11060 and Trichoderma asperellum GDFS1009 enhanced pathogen-inhibition and amino acid yield. Microb. Cell Factor. 2018, 17, 155. [Google Scholar] [CrossRef]
- Wang, Y.; Pruitt, R.N.; Nürnberger, T.; Wang, Y. Evasion of plant immunity by microbial pathogens. Nat. Rev. Microbiol. 2022, 20, 449–464. [Google Scholar] [CrossRef]
- Ma, Q.; Cong, Y.; Feng, L.; Liu, C.; Yang, W.; Xin, Y.; Chen, K. Effects of mixed culture fermentation of Bacillus amyloliquefaciens and Trichoderma longibrachiatum on its constituent strains and the biocontrol of tomato Fusarium wilt. J. Appl. Microbiol. 2022, 132, 532–546. [Google Scholar] [CrossRef]
- Zhang, X.; Lin, W.; Li, Q.; Liu, R.; Liu, J.; Wang, M.; Wang, Y.F.; Zhao, D.; Zhang, C. Construction and Optimization of a Co-culture System of Anti-Phytophth nicotianae Trichoderma asperellum HG1 and Bacillus subtilis Tpb55. Chin. Tob. Sci. 2022, 43, 61–68. [Google Scholar] [CrossRef]
- Wei, Y. Study on Isolation and Identification of Bacillus subtilis and Its Synergism with Chaetomium globosum for Control of Cucumber Fusarium Wilt. Ph.D. Thesis, Shandong Agricultural University, Tai’an, China, 2019. [Google Scholar]
- Kaddurah-Daouk, R.; Krishnan, K.R. Metabolomics: A global biochemical approach to the study of central nervous system diseases. Neuropsychopharmacology 2009, 34, 173–186. [Google Scholar] [CrossRef]
- Wishart, D.S. Applications of metabolomics in drug discovery and development. Drugs R D 2008, 9, 307–322. [Google Scholar] [CrossRef]
- Dunn, W.B.; Ellis, D.I. Metabolomics: Current analytical platforms and methodologies. TrAC Trends Anal. Chem. 2005, 24, 285–294. [Google Scholar] [CrossRef]
- Xu, W. Different Analysis in Camel Milk Components before and after Fermentation Based on Non-Targeted Metabolomics. Ph.D. Thesis, Inner Mongolia Agricultural University, Inner Mongolia, China, 2023. [Google Scholar]
- Xu, W.; Wang, H.; Lv, Z.; Shi, Y.; Wang, Z. Antifungal activity and functional components of cell-free supernatant from Bacillus amyloliquefaciens LZN01 inhibit Fusarium oxysporum f. sp. niveum growth. Biotechnol. Biotechnol. Equip. 2019, 33, 1042–1052. [Google Scholar] [CrossRef]
- Fan, L.; Guo, Y.; Zhao, X.; Sun, M.; Li, S. Biocontrol activities and metabolome analysis of microsclerotia fermentation filtrate of Purpureocillium lilacinum. Chin. J. Biol. Control 2022, 38, 821–830. [Google Scholar] [CrossRef]
- Hao, J.; Wuyun, D.; Xi, X.; Dong, B.; Wang, D.; Quan, W.; Zhang, Z.; Zhou, H. Application of 6-pentyl-α-pyrone in the nutrient solution used in tomato soilless cultivation to inhibit Fusarium oxysporum HF-26 growth and development. Agronomy 2023, 13, 1210. [Google Scholar] [CrossRef]
- Hu, J.; Wang, D.; Dong, B.; Meng, H.; Zhao, J.; Zhou, H. The inhibitory effect of the volatile compound 2-methyl benzothiazole on pathogenic fungi Sclerotinia sclerotiorum and Botrytis cinerea. J. Plant Prot. 2021, 48, 781–788. [Google Scholar] [CrossRef]
- He, S. Preparation of Compound Bacteria for Biocontrol of Potato Verticillium Wilt. Ph.D. Thesis, Inner Mongolia Agricultural University, Inner Mongolia, China, 2021. [Google Scholar]
- Lee, T.; Park, D.; Kim, K.; Lim, S.M.; Yu, N.H.; Kim, S.; Kim, H.Y.; Jung, K.S.; Jang, J.Y.; Park, J.C. Characterization of Bacillus amyloliquefaciens DA12 showing potent antifungal activity against mycotoxigenic Fusarium species. Plant Pathol. J. 2017, 33, 499–507. [Google Scholar] [CrossRef]
- Choi, H.W.; Ahsan, S.M. Biocontrol activity of Aspergillus terreus ANU-301 against two distinct plant diseases, tomato Fusarium Wilt and potato soft rot. Plant Pathol. J. 2022, 38, 33–45. [Google Scholar] [CrossRef] [PubMed]
- Hu, Y.; Yu, Q.; Guo, X.; Wei, X.; Wei, K.; Miu, J. Analysis of different metabolites in different parts of Valeriana jatamansi jones based on non-targeted metabolomics. Mod. Chin. Med. 2023, 25, 1619–1626. [Google Scholar] [CrossRef]
- Liang, W.; Zheng, F.; Chen, T.; Zhang, X.; Xia, Y.; Li, Z.; Lu, X.; Zhao, C.; Xu, G. Nontargeted screening method for veterinary drugs and their metabolites based on fragmentation characteristics from ultrahigh-performance liquid chromatography-high-resolution mass spectrometry. Food Chem. 2022, 369, 130928. [Google Scholar] [CrossRef] [PubMed]
- Guo, X.; Li, K.; Sun, Y.; Zhang, L.; Hu, X.; Xie, H. Allelopathic effects and identification of alleochemicals in grape root exudates. Acta Hortic. Sin. 2010, 37, 861–868. [Google Scholar] [CrossRef]
- Jin, M.; Ding, K.; Lin, M.; Wu, S.; Su, F. The extraction and purification of the antifungal substances to the Fusarium oxysporum from the Paenibacillus polymyxa S960. J. Anhui Agric. Univ. 2020, 47, 798–804. [Google Scholar] [CrossRef]
- Wang, W.; Shi, G.; Su, G.; Mou, X.; Zhu, Y.; Yang, H.; LI, M. Analysis of inhibitory effect Aconitic Acid against Fusarium oxysporum f.sp. lili. Acta Agric. Boreali-Occident. Sin. 2022, 31, 224–232. [Google Scholar]
- Gong, Y.; Zhou, G.; Peng, S.; Wu, Z.; Liu, J.; Huang, H.; Chen, Z. Differential analysis of the metabolites on Citrus Pericarp Brownspot based on untargeted metabolomics. J. Chin. Inst. Food Sci. Technol. 2022, 22, 316–324. [Google Scholar] [CrossRef]
- Kromann, P.; Miethbauer, T.; Ortiz, O.; Forbes, G. Review of potato biotic constraints and experiences with integrated pest management interventions. In Integrated Pest Management; Pimentel, D., Peshin, R., Eds.; Springer: Dordrecht, The Netherlands, 2014. [Google Scholar] [CrossRef]
- Zhou, H.; Chu, G.; Duan, H.; Yang, S.; Chen, S.; Zhang, J. Effects of co-culture of two biocontrol bacteria on inhibition of Rhizocto solani and growth promotion of maize seedings. J. Anhui Sci. Technol. Univ. 2023, 37, 41–48. [Google Scholar] [CrossRef]
- Hu, H.; Wang, K.; Li, M.; Zhou, R. Efficacy test of several Bacillus subtilis fermentation broth to control strawberry disease. Hubei Agric. Sci. 2002, 2, 52. [Google Scholar]
- Lv, J.; Zhang, C.; Qu, T.; Liu, Y.; Hu, S.; Zhao, Y.; Zhang, B. Inhibitory effect of Trichoderma asperellum HG1 and Bacillus subtilis Tpb55 on Botrytis cinerea. China Plant Prot. 2022, 42, 21–25. [Google Scholar]
- Karuppiah, V.; Vallikkannu, M.; Li, T.; Chen, J. Simultaneous and sequential based co-fermentations of Trichoderma asperellum GDFS1009 and Bacillus amyloliquefaciens 1841: A strategy to enhance the gene expression and metabolites to improve the bio-control and plant growth promoting activity. Microb. Cell Fact. 2019, 18, 185. [Google Scholar] [CrossRef] [PubMed]
- Wang, Y.; Chen, Y.; Fan, L.; Ma, G.; Li, S.; Sun, M.; Bao, Z. Biocontrol and growth-promoting activities of Clonostachys rosea and Bacillus subtilis. Chin. J. Biol. Control 2022, 38, 222–229. [Google Scholar] [CrossRef]
- Chen, Y. Study on Dynamic Combinatorial Chemistry of Vancomycin. Ph.D. Thesis, Peking Union Medical College, Beijing, China, 2009. [Google Scholar]
- Guo, J. Effects of isotretinoin combined with tacrolimus ointment on adverse reactions in patients with seborrheic dermatitis. Syst. Med. 2023, 8, 155–158. [Google Scholar] [CrossRef]
- Kanter, U.; Usadel, B.; Guerineau, F.; Li, Y.; Pauly, M.; Tenhaken, R. The inositol oxygenase gene family of Arabidopsis is involved in the biosynthesis of nucleotide sugar precursors for cell-wall matrix polysaccharides. Planta 2005, 221, 243–254. [Google Scholar] [CrossRef]
- Peng, J.; Dong, B.; Wang, D.; Zhou, H. Analysis of differential metabolites of sunflower induced by virulent Verticillium dahlia V33 and hypovirulent Gibellulopsis nigrescens Vn-1. J. Phytopathol. 2022, 170, 349–358. [Google Scholar] [CrossRef]
- Xia, F.; Zhang, C.; Wu, Z.; Cao, S.; Wu, P. Antibacterial effect and mechanism of citric acid on spoilage bacteria edible mushroom. J. Shaanxi Univ. Sci. Technol. 2023, 41, 40–45. [Google Scholar] [CrossRef]
- Chen, C.; Wang, L.; Adilamu, A.; Zhang, N.; Zhang, W.; Dong, H. The inhibitory activity of copper-aspartate complexes on Erwinia amylovora and its growth-promoting effect on plants. J. Tarim Univ. 2023, 35, 44–51. [Google Scholar]
- Xia, J.; Wishart, D.S. Web-based inference of biological patterns, functions and pathways from metabolomic data using MetaboAnalyst. Nat. Protoc. 2011, 6, 743–760. [Google Scholar] [CrossRef] [PubMed]

| Treatments | Inoculation Amount | Morphology | |
|---|---|---|---|
| (mL) | |||
| B. subtilis | T. asperellum | ||
| ZWZ-19 | PT-29 | ||
| CK | 0 | 0 | None |
| B | 3 | 0 | Milky white suspension |
| T | 0 | 3 | Beige suspension with dense mycelium |
| B1T1 | 1.5 | 1.5 | Bright yellow suspension with high viscosity mycelium |
| B2T1 | 2 | 1 | Yellowish suspension with small amounts of mycelium |
| B1T2 | 1 | 2 | Dark yellow suspension with slightly more mycelium |
| Types | B vs. T | B1T1 vs. B | B1T1 vs. T | ||||||
|---|---|---|---|---|---|---|---|---|---|
| Total | Upregulation Quantity | Downregulation Quantity | Total | Upregulation Quantity | Downregulation Quantity | Total | Upregulation Quantity | Downregulation Quantity | |
| Organoheterocyclic compounds | 20 | 14 | 6 | 22 | 11 | 11 | 3 | 2 | 1 |
| Benzenoids | 10 | 4 | 6 | 16 | 14 | 2 | 0 | 0 | 0 |
| Lipids and lipid-like molecules | 16 | 8 | 8 | 20 | 10 | 10 | 10 | 5 | 5 |
| Amino acids | 12 | 9 | 3 | 16 | 13 | 5 | 17 | 10 | 7 |
| Nucleosides | 5 | 4 | 1 | 6 | 3 | 3 | 1 | 1 | 0 |
| Organic acids | 3 | 1 | 2 | 4 | 2 | 2 | 1 | 0 | 1 |
| Others | 5 | 2 | 3 | 6 | 5 | 1 | 2 | 2 | 0 |
| Total | 71 | 42 | 29 | 90 | 58 | 34 | 34 | 20 | 14 |
| Cultivation | Compound | VIP | p-Value |
|---|---|---|---|
| B | L-Malate | 1.39 × 10−8 | 1.58013773 |
| B | 1,3-Dimethyluracil | 1.25 × 10−6 | 1.546674027 |
| B | Phenylacetylglutamine | 6.69 × 10−6 | 1.505866262 |
| B | L-Methionine sulfoxide | 8.67 × 10−4 | 1.528419213 |
| B | Kojic acid | 1.83 × 10−3 | 1.577939364 |
| B | L-Asparagine | 8.65 × 10−3 | 1.523708247 |
| B1T1 | N-Acetyl-L-tyrosine | 2.86 × 10−7 | 1.570824956 |
| B1T1 | D-Ala-D-Ala | 2.15 × 10−5 | 1.571912954 |
| B1T1 | 2-Hydroxyphenylalanine | 1.12 × 10−5 | 1.667481741 |
| B1T1 | L-Tyrosine | 1.61 × 10−4 | 1.539024139 |
| B1T1 | LL-2,6-Diaminopimelate | 1.90 × 10−4 | 1.560211492 |
| B1T1 | Isotretinoin | 1.93 × 10−4 | 1.577901393 |
| B1T1 | 8-Aminooctanoic acid | 1.16 × 10−3 | 1.539511272 |
| B1T1 | Urocanic acid | 1.97 × 10−3 | 1.606733748 |
| B1T1 | Gly-Phe | 3.15 × 10−3 | 1.607442416 |
| T | Asp-glu | 6.00 × 10−6 | 1.611481292 |
| T | Thr-Leu | 2.14 × 10−4 | 1.666121562 |
| T | N-acetyl-L-ornithine | 2.69 × 10−4 | 1.677736612 |
| T | Pyridoxamine | 2.35 × 10−3 | 1.599751113 |
| T | Nicotinuric Acid | 3.47 × 10−3 | 1.484749249 |
Disclaimer/Publisher’s Note: The statements, opinions and data contained in all publications are solely those of the individual author(s) and contributor(s) and not of MDPI and/or the editor(s). MDPI and/or the editor(s) disclaim responsibility for any injury to people or property resulting from any ideas, methods, instructions or products referred to in the content. |
© 2024 by the authors. Licensee MDPI, Basel, Switzerland. This article is an open access article distributed under the terms and conditions of the Creative Commons Attribution (CC BY) license (https://creativecommons.org/licenses/by/4.0/).
Share and Cite
Hao, J.; Wang, Z.; Zhao, Y.; Feng, S.; Cui, Z.; Zhang, Y.; Wang, D.; Zhou, H. Inhibition of Potato Fusarium Wilt by Bacillus subtilis ZWZ-19 and Trichoderma asperellum PT-29: A Comparative Analysis of Non-Targeted Metabolomics. Plants 2024, 13, 925. https://doi.org/10.3390/plants13070925
Hao J, Wang Z, Zhao Y, Feng S, Cui Z, Zhang Y, Wang D, Zhou H. Inhibition of Potato Fusarium Wilt by Bacillus subtilis ZWZ-19 and Trichoderma asperellum PT-29: A Comparative Analysis of Non-Targeted Metabolomics. Plants. 2024; 13(7):925. https://doi.org/10.3390/plants13070925
Chicago/Turabian StyleHao, Jianxiu, Zhen Wang, Yuanzheng Zhao, Shujie Feng, Zining Cui, Yinqiang Zhang, Dong Wang, and Hongyou Zhou. 2024. "Inhibition of Potato Fusarium Wilt by Bacillus subtilis ZWZ-19 and Trichoderma asperellum PT-29: A Comparative Analysis of Non-Targeted Metabolomics" Plants 13, no. 7: 925. https://doi.org/10.3390/plants13070925
APA StyleHao, J., Wang, Z., Zhao, Y., Feng, S., Cui, Z., Zhang, Y., Wang, D., & Zhou, H. (2024). Inhibition of Potato Fusarium Wilt by Bacillus subtilis ZWZ-19 and Trichoderma asperellum PT-29: A Comparative Analysis of Non-Targeted Metabolomics. Plants, 13(7), 925. https://doi.org/10.3390/plants13070925






